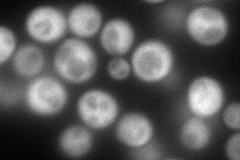
YEL058W
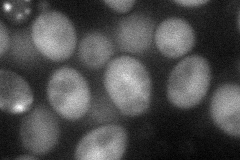
YEL058W

View description
Essential N-acetylglucosamine-phosphate mutase; converts GlcNAc-6-P to GlcNAc-1-P, which is a precursor for the biosynthesis of chitin and for the formation of N-glycosylated mannoproteins and glycosylphosphatidylinositol anchors
Localization:
Intensity:
Fold change:
Significance:
-
C’ GFP library in SD

cytosol47.02 -
N' NOP1pr-GFP in SD
cytosol181.409 -
N' TEF2pr-mCherry in SD

missing0 -
N' NATIVEpr-GFP in SD

cytosol41.7329 -
N' TEF2pr-VC and Cyto-VN in SD
cytosol59.7523 -
C’ GFP library in SD+DTT

cytosol76.261.62Yes -
C’ GFP library in SD+H2O2

cytosol57.581.22No -
C’ GFP library in Starvation Media

cytosol57.441.22No -
C’ GFP library on the background of Pup2-DaMP

N/A -
C’ GFP library on the background of CCT mutant

N/A0N/AYes
